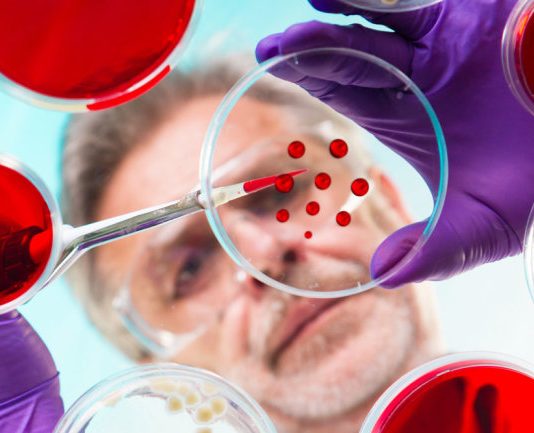
Что такое опухолевые маркеры?

Это Вам пригодится
Как противозачаточные свечи лучше выбрать как средство местной контрацепции?
Качественные бассейны от компании vashbas по выгодной цене
Что делать, когда пропущен прием противозачаточной таблетки: план действий, возможные варианты
Комбинированные оральные контрацептивы (КОК ) обладают надежным противозачаточным действием, многим женщинам они помогают решить проблемы с кожей и волосами, воздействуя на гормональный дисбаланс изнутри. Для достижения необходимого эффекта нужна большая приверженность терапии, пропуск таблетки чреват нежелательной беременностью. Согласно исследованиям фармакологических компаний-производителей КОКов, женщины довольно часто забывают о приеме контрацептива, поэтому специально был разработан алгоритм действий.
Малярно-кузовные работы и их качество
Противозачаточные таблетки для женщин от 40 лет
Для женщин в возрасте 40 лет проблема контрацепции так же актуальна, как и для молодых девушек. В этот период существует вероятность нежелательной беременности, несмотря на то, что функции репродуктивной системы постепенно угасают. В настоящее время самым эффективным методом контрацепции является прием противозачаточных таблеток. Защита от беременности при применении оральных контрацептивов составляет 97–99,9%. Но это не единственное их достоинство.